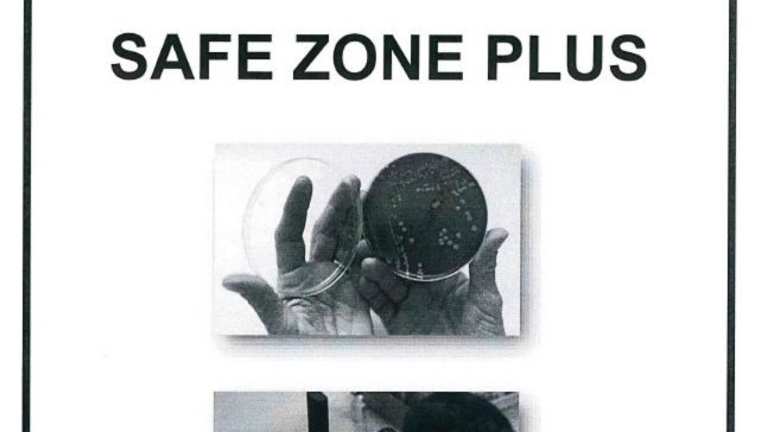

Das Hotel allgemein
Das Metaxas Mansion ist eine charmante Unterkunft mit Bergblick, die sich perfekt für einen entspannten Urlaub eignet. Mit einer Terrasse und einer Veranda können die Gäste die umliegende Natur und die frische Luft genießen. Das Hotel bietet eine günstige Lage, nur 13 km vom Adventure Mountain Park entfernt. Mit kostenfreiem WLAN in allen Bereichen bleiben die Gäste immer verbunden. Die Unterkunft ist klimatisiert und verfügt über einen gemütlichen Sitzbereich, einen Flachbild-TV, einen DVD-Player und eine gut ausgestattete Küche. Handtücher und Bettwäsche werden gestellt, um den Komfort der Gäste zu gewährleisten. In der Nähe befindet sich auch das Kloster Kykkos, das einen Besuch wert ist. Der internationale Flughafen Paphos ist etwa 72 km entfernt.
Die Lage des Hotels
Das Metaxas Mansion liegt in einer malerischen Umgebung mit Blick auf die Berge. Es ist eine ideale Wahl für Naturliebhaber und Abenteuerlustige, da der Adventure Mountain Park nur 13 km entfernt ist. Der Sparti Adventure Park ist ebenfalls in der Nähe, etwa 27 km entfernt. Gäste können die Schönheit der Umgebung erkunden und gleichzeitig die Ruhe und den Frieden genießen. Das Kloster Kykkos, das für seine historische Bedeutung bekannt ist, liegt etwa 32 km entfernt. Der internationale Flughafen Paphos ist der nächstgelegene Flughafen und etwa 72 km entfernt.
Zimmer / Unterbringung im Hotel
Das Metaxas Mansion bietet komfortable Unterkünfte mit einer gemütlichen Atmosphäre. Jedes Zimmer ist klimatisiert und verfügt über einen Sitzbereich, in dem die Gäste sich entspannen können. Ein Flachbild-TV und ein DVD-Player stehen ebenfalls zur Verfügung, um Unterhaltungsmöglichkeiten zu bieten. Die Küche ist gut ausgestattet mit einem Kühlschrank, so dass die Gäste ihre eigenen Mahlzeiten zubereiten können. Handtücher und Bettwäsche werden gestellt, um den Komfort der Gäste zu gewährleisten.
Gastronomie im Hotel
Das Metaxas Mansion bietet keine Verpflegungsmöglichkeiten vor Ort. Gäste haben jedoch die Möglichkeit, ihre eigenen Mahlzeiten in der gut ausgestatteten Küche zuzubereiten. In der Umgebung finden sich auch Restaurants, in denen die Gäste lokale Spezialitäten genießen können.
Sport und Unterhaltung
Das Metaxas Mansion bietet eine ruhige und entspannte Atmosphäre, in der die Gäste die umliegende Natur genießen können. Gäste können die Terrasse und die Veranda nutzen, um frische Luft zu schnappen und den Blick auf die Berge zu genießen. In der Umgebung gibt es auch Möglichkeiten für Outdoor-Aktivitäten wie Wandern und Radfahren.